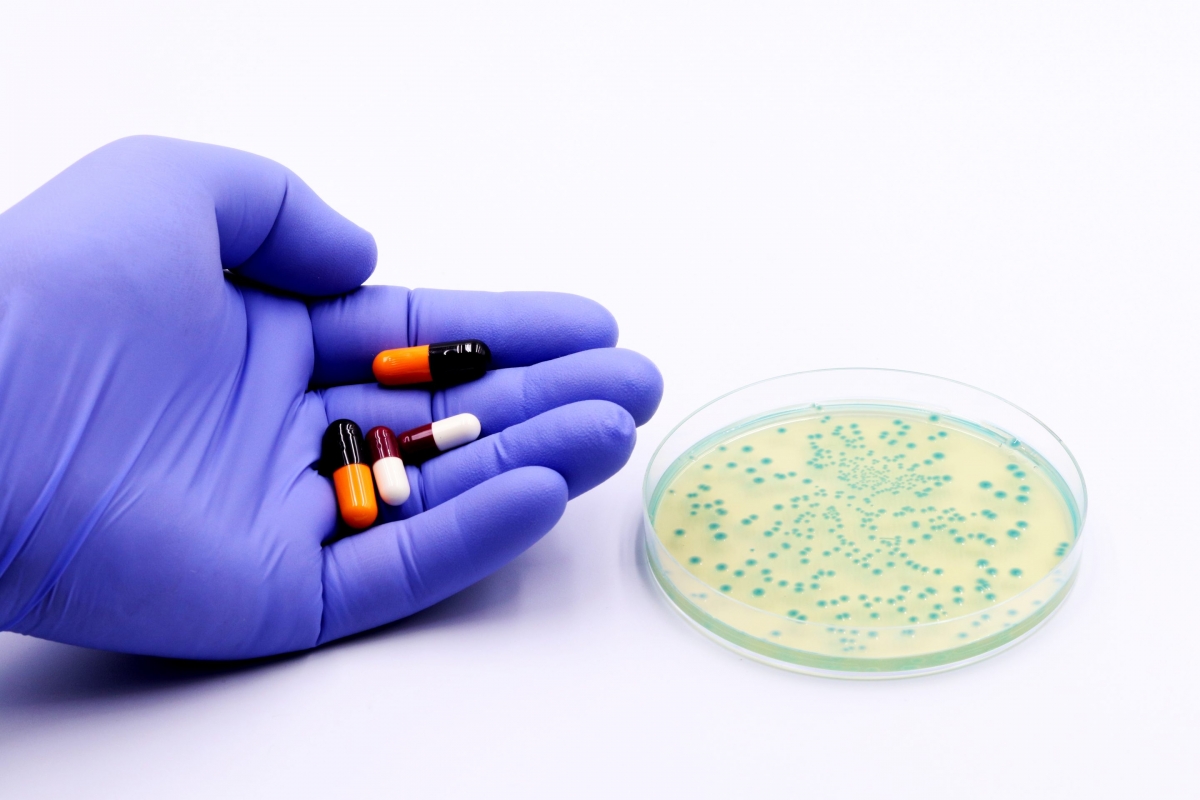

# Tổ chức Y tế Thế giới (WHO) cảnh báo hiện không có đủ các xét nghiệm và phương pháp điều trị mới để giải quyết tình trạng vi khuẩn kháng thuốc ngày càng gia tăng. Theo WHO, kháng thuốc kháng sinh (AMR) là tình trạng xảy ra khi các vi sinh vật như vi khuẩn, virus và ký sinh trùng không còn phản ứng với thuốc kháng khuẩn. AMR ngày càng trở nên phổ biến, đặc biệt là các loại vi khuẩn có hại kháng thuốc kháng sinh ngày càng tăng. WHO nhận định đây là một trong những mối đe dọa sức khỏe cộng đồng hàng đầu và được cho là gây ra hơn 1 triệu ca tử vong mỗi năm.
# Các phương pháp giải rượu ở Hàn Quốc đang tạo biến động trên làn sóng chăm sóc sức khỏe toàn cầu. Hàn Quốc là quốc gia tung ra thị trường nhiều sản phẩm giải rượu nhất trong vòng 5 năm qua. Sự phổ biến của văn hóa Hàn Quốc đã thúc đẩy sự quan tâm và nhu cầu về sản phẩm giải rượu trên thị trường quốc tế như Đông Nam Á và nhiều nơi khác. Cây chỉ cụ, trong tiếng Hàn là heotgae, đang nổi lên như một thành phần truyền thống chủ yếu trong ngành sản xuất thuốc giải rượu. Các nhà nghiên cứu y khoa vẫn còn hoài nghi về chất lượng của phương pháp giải rượu từ heotgae. Tuy nhiên, với nhiều người, các biện pháp giải rượu có lẽ không hoàn toàn dựa trên khoa học mà chủ yếu nhằm mang lại cảm giác dễ chịu, duy trì thói quen và gắn liền với văn hóa uống rượu chung.
# Bệnh viện Quân y 175, TP.HCM cho biết, vừa thực hiện thành công ca ghép gan cấp cứu đặc biệt lần thứ 9, cứu sống một Thiếu tá Quân nhân chuyên nghiệp – y sĩ quân y. Theo đó, Thiếu tá, y sĩ Đỗ Văn Công công tác tại một đơn vị phía Nam, có tiền sử viêm gan B mạn tính. Trong giờ phút sinh tử, người anh trai ruột tình nguyện hiến gan cứu em. Chỉ trong chưa đầy 48 giờ, Bệnh viện Quân y 175 đã hoàn tất toàn bộ quy trình sàng lọc, hội chẩn và chuẩn bị phẫu thuật. Cuộc phẫu thuật kéo dài hơn 8 tiếng, huy động hàng trăm y bác sĩ và kỹ thuật viên từ nhiều chuyên khoa. Kết quả, lá gan ghép hoạt động tốt ngay sau phẫu thuật. Chỉ sau 24 giờ, bệnh nhân tỉnh táo, các chỉ số hồi phục tích cực. Người hiến gan hiện sức khỏe ổn định, trở lại sinh hoạt bình thường.
# Trong hai ngày liên tiếp, Trung tâm Y tế Đông Triều (Quảng Ninh) đã cấp cứu hai bệnh nhân bị sốc phản vệ nặng do uống thuốc tự mua. Các loại thuốc thường gây ra tình trạng này là kháng sinh, thuốc giảm đau - hạ sốt và cả những loại thuốc không rõ nguồn gốc, thuốc “truyền miệng” hay quảng cáo trên mạng xã hội. Việc tự ý sử dụng thuốc không chỉ làm tăng nguy cơ sốc phản vệ, mà còn gây tổn hại gan, thận và nhiều biến chứng khó lường. Khuyến cáo đưa ra là: Người dân tuyệt đối không mua và uống thuốc khi chưa có sự thăm khám của các bác sĩ, đặc biệt là những người có tiền sử dị ứng. Việc cấp cứu sốc phản vệ phải được thực hiện bởi các y, bác sĩ có chuyên môn và dụng cụ hỗ trợ, hộp thuốc chống sốc.
# Xã Yên Lãng (HN) tổ chức khám sức khỏe miễn phí cho người cao tuổi trên địa bàn xã. Đợt khám sức khỏe năm nay, xã Yên Lãng tổ chức khám sức khỏe cho gần 12.000 người dân từ 60 tuổi trở lên. Thời gian khám cho người dân đến hết tháng 10-2025. Theo đó, người cao tuổi được đội ngũ y, bác sĩ Bệnh viện Đa khoa Mê Linh và Trạm Y tế xã trực tiếp khám, chữa bệnh và tư vấn sức khỏe. Đáng chú ý, toàn bộ dữ liệu khám bệnh cho người cao tuổi được nhập vào hệ thống hồ sơ sức khỏe điện tử, kết nối với phần mềm quản lý chung của thành phố. Như vậy, mỗi người cao tuổi sẽ có một “bản lý lịch sức khỏe” được theo dõi liên tục, phục vụ cho việc khám chữa bệnh sau này.
# Gai cột sống hay còn gọi là thoái hóa cột sống, trong đó có sự hình thành các phần xương mọc ra (gai xương) ở phía ngoài và hai bên của cột sống khi có các tổn thương ở đĩa đệm, sụn khớp, dây chằng do viêm khớp, chấn thương và lắng đọng calci ở cột sống. Biểu hiện ban đầu là hiện tượng cứng, mỏi cột sống, càng về sau, vùng gai cột sống càng đau nhiều thậm chí là cảm giác đau buốt. Đặc biệt khi bệnh nhân vận động như đi lại hoặc đứng lên. Đau có thể lan ra các chi, dọc xuống 2 chân, đôi khi có cảm giác tê bì và mất cảm giác ở tay và chân. Một vài trường hợp người bệnh có biểu hiện rối loạn thần kinh như tụt huyết áp, tăng tiết mồ hôi, mất cân bằng khó thở. Gai cột sống không chỉ gây đau nhức mà còn ảnh hưởng trực tiếp đến chất lượng sống của người bệnh. Để điều trị, người bệnh cần phối hợp nhiều biện pháp khác nhau: sử dụng đông tây y kết hợp, phương pháp trị liệu, tập thể dục, dinh dưỡng.
Bình luận